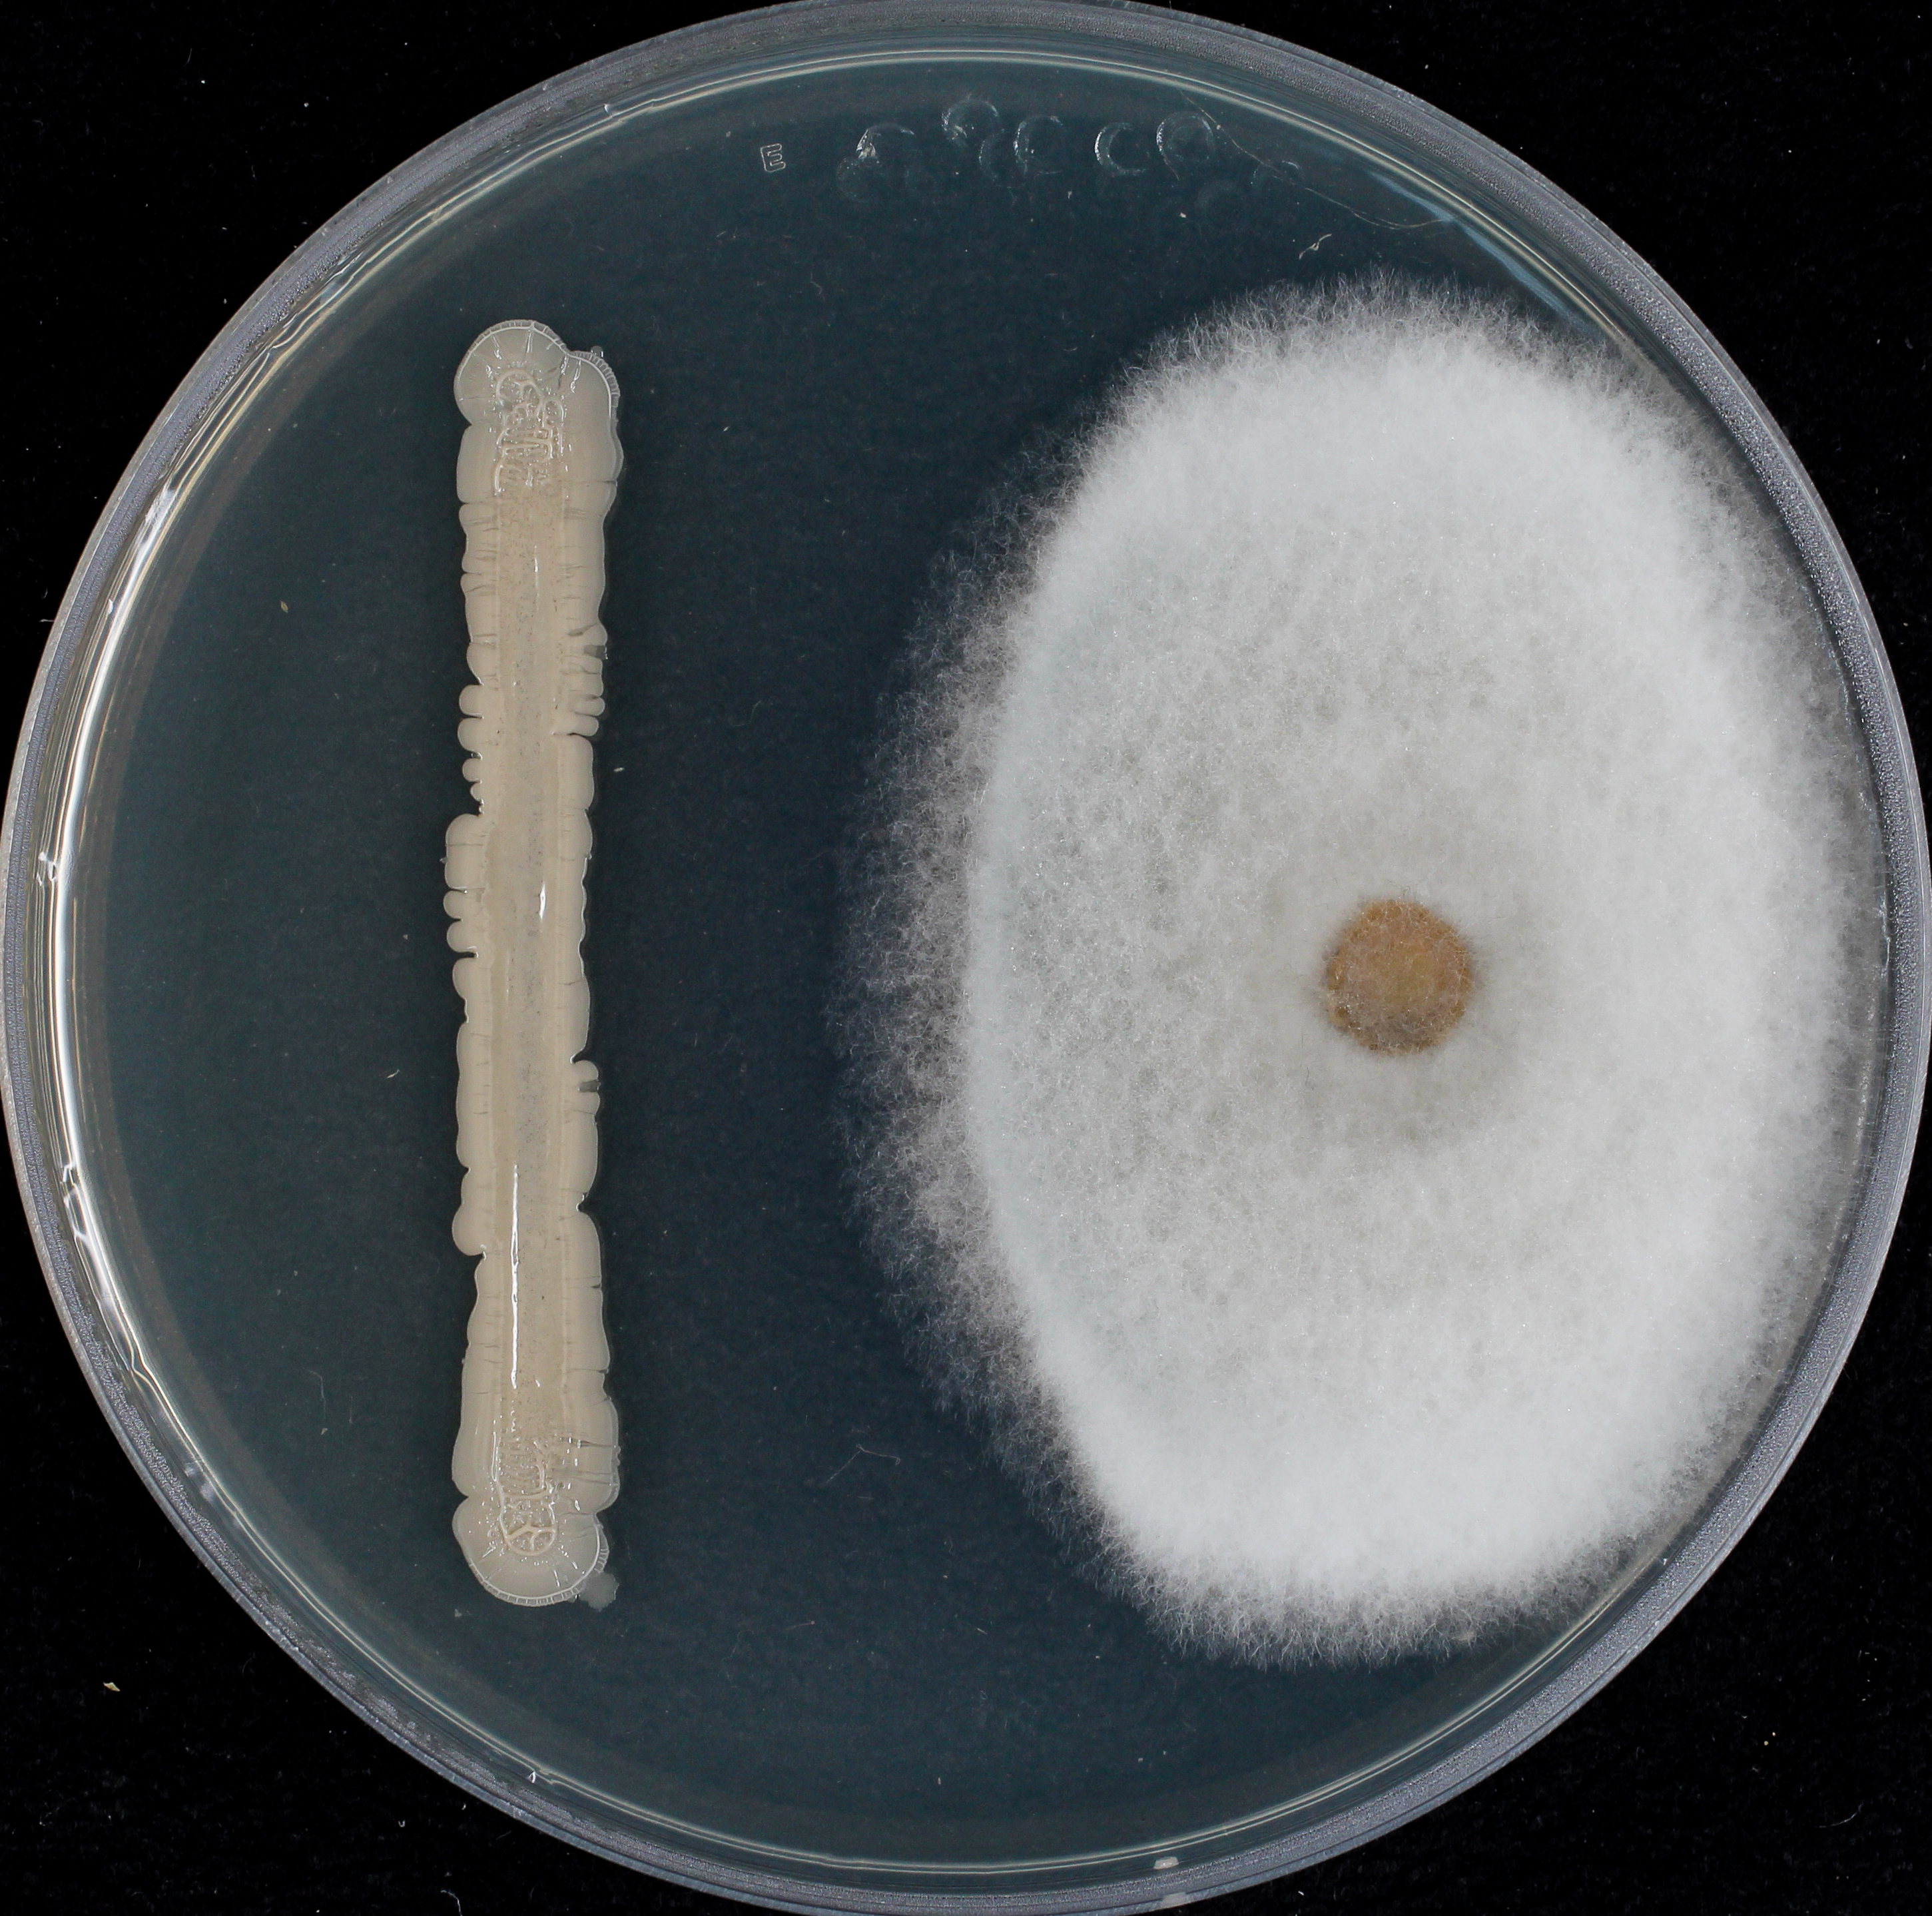
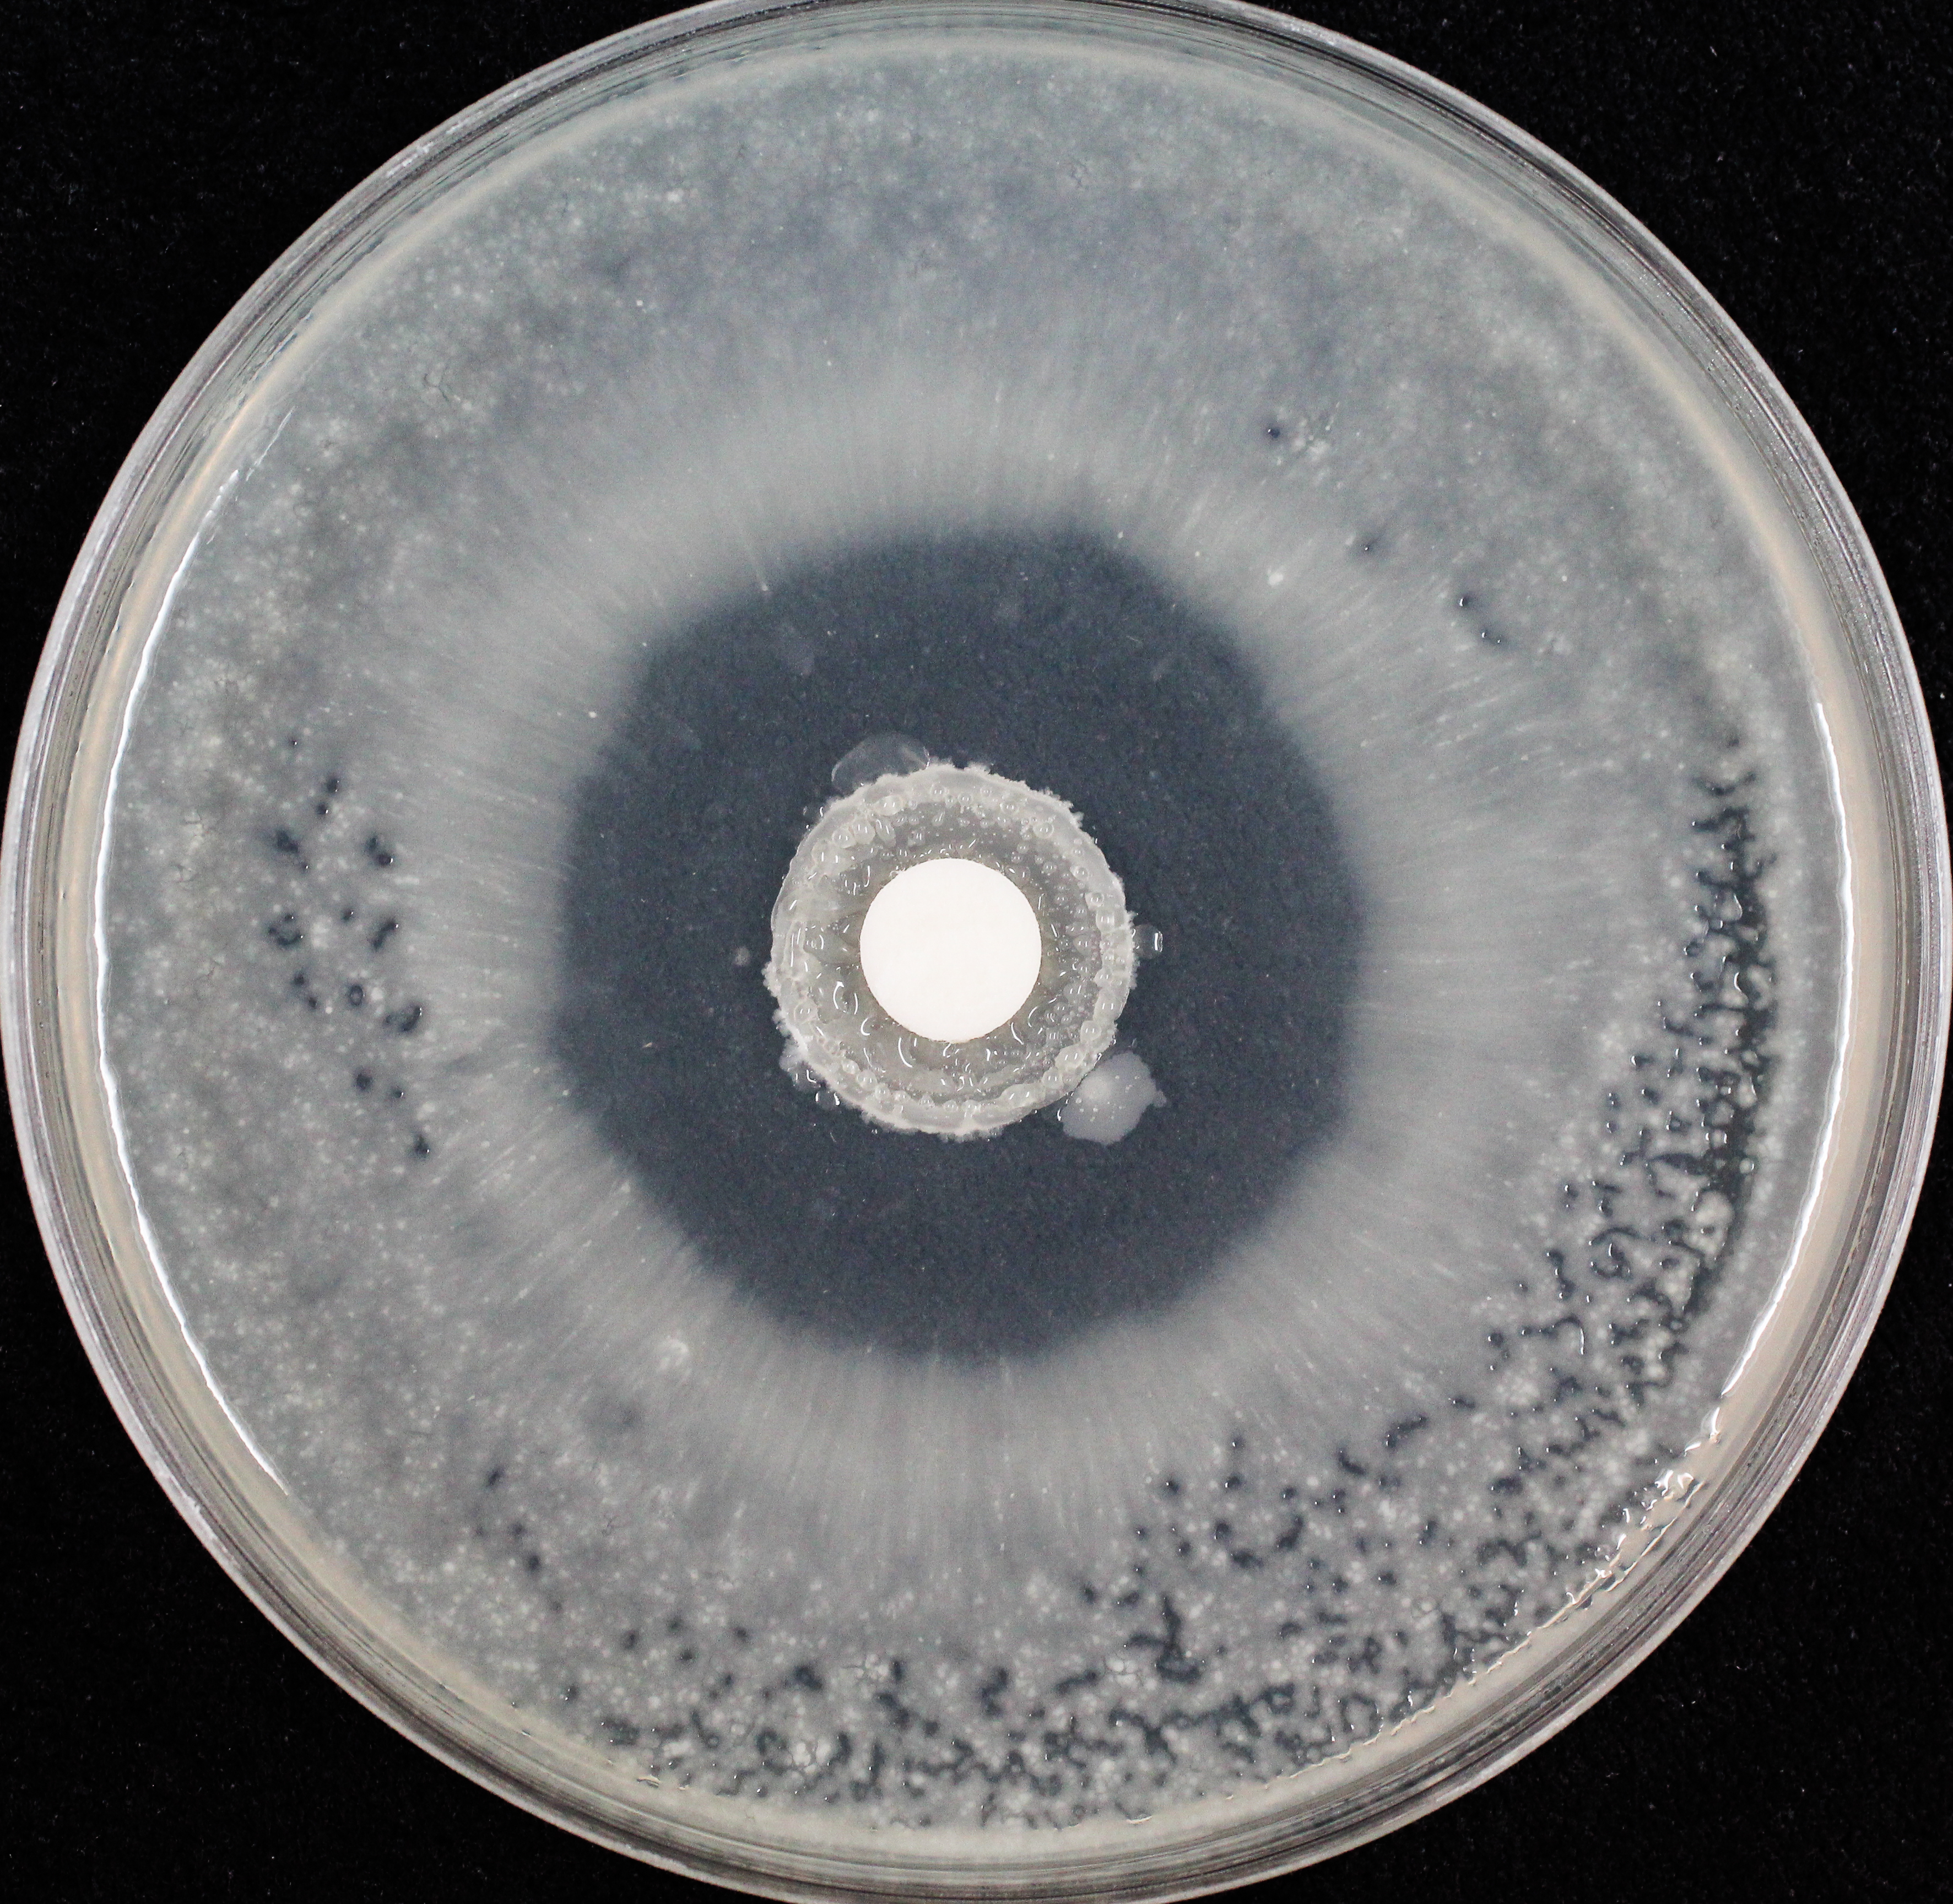
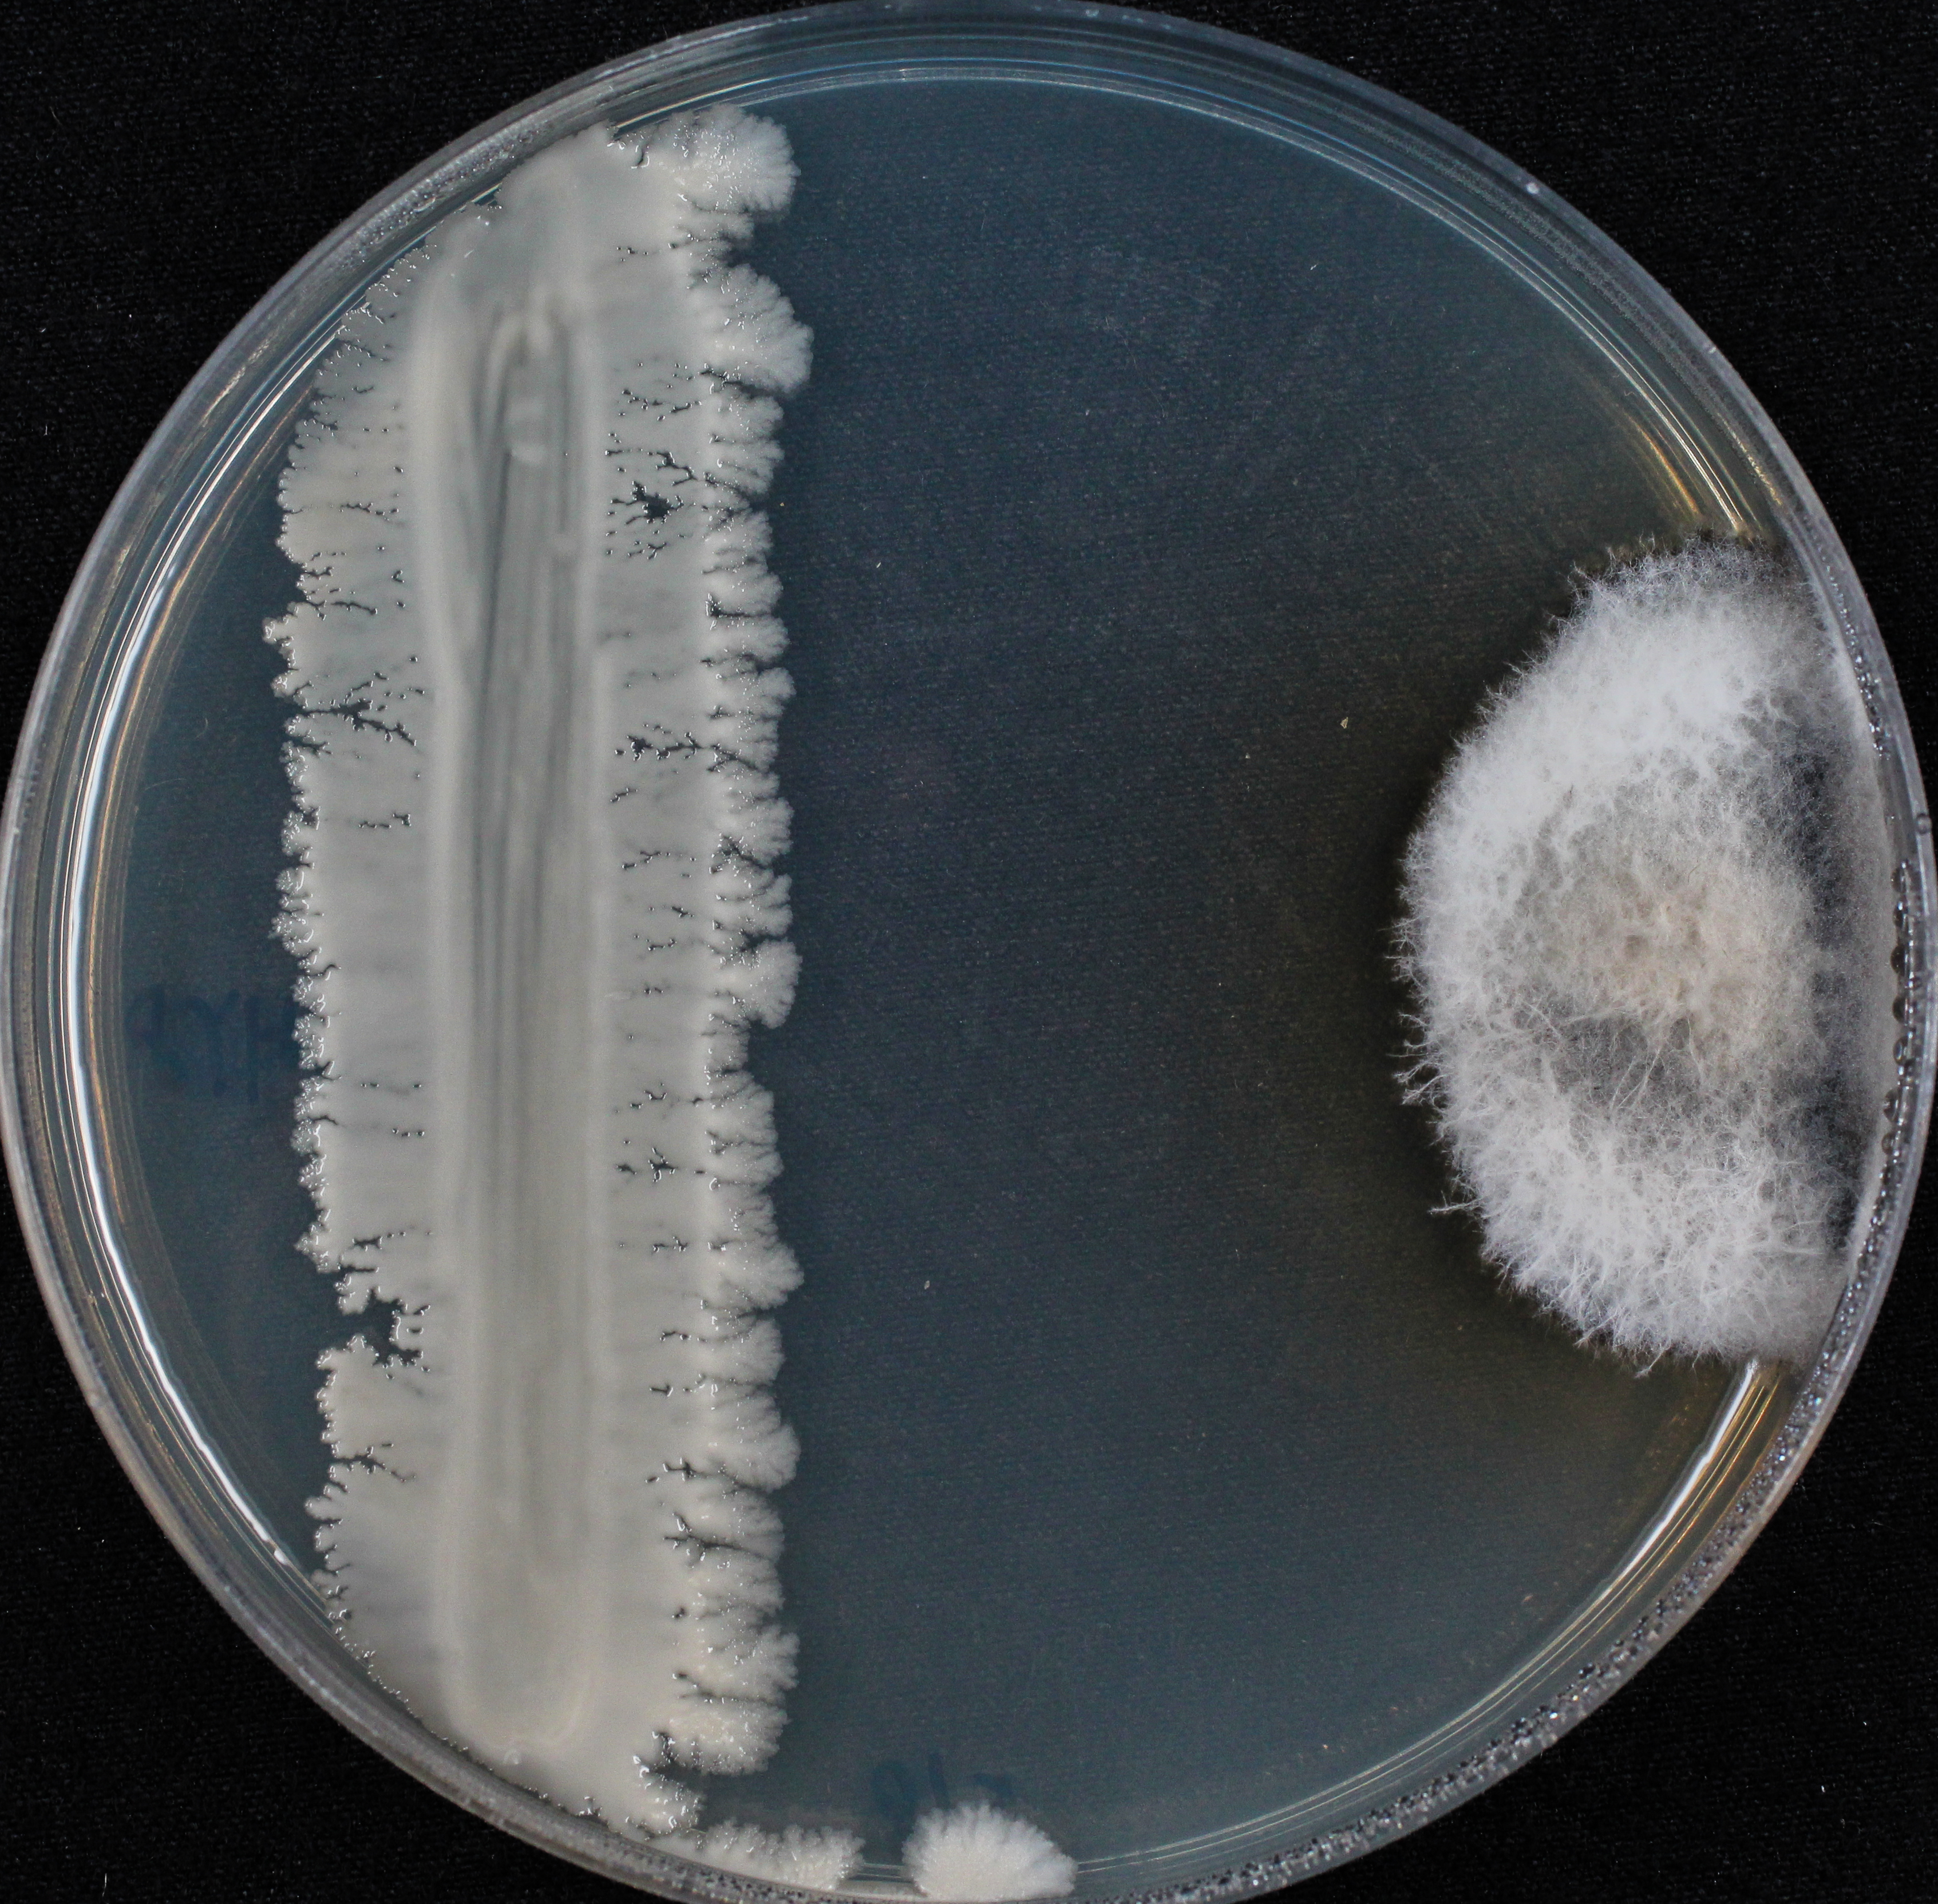
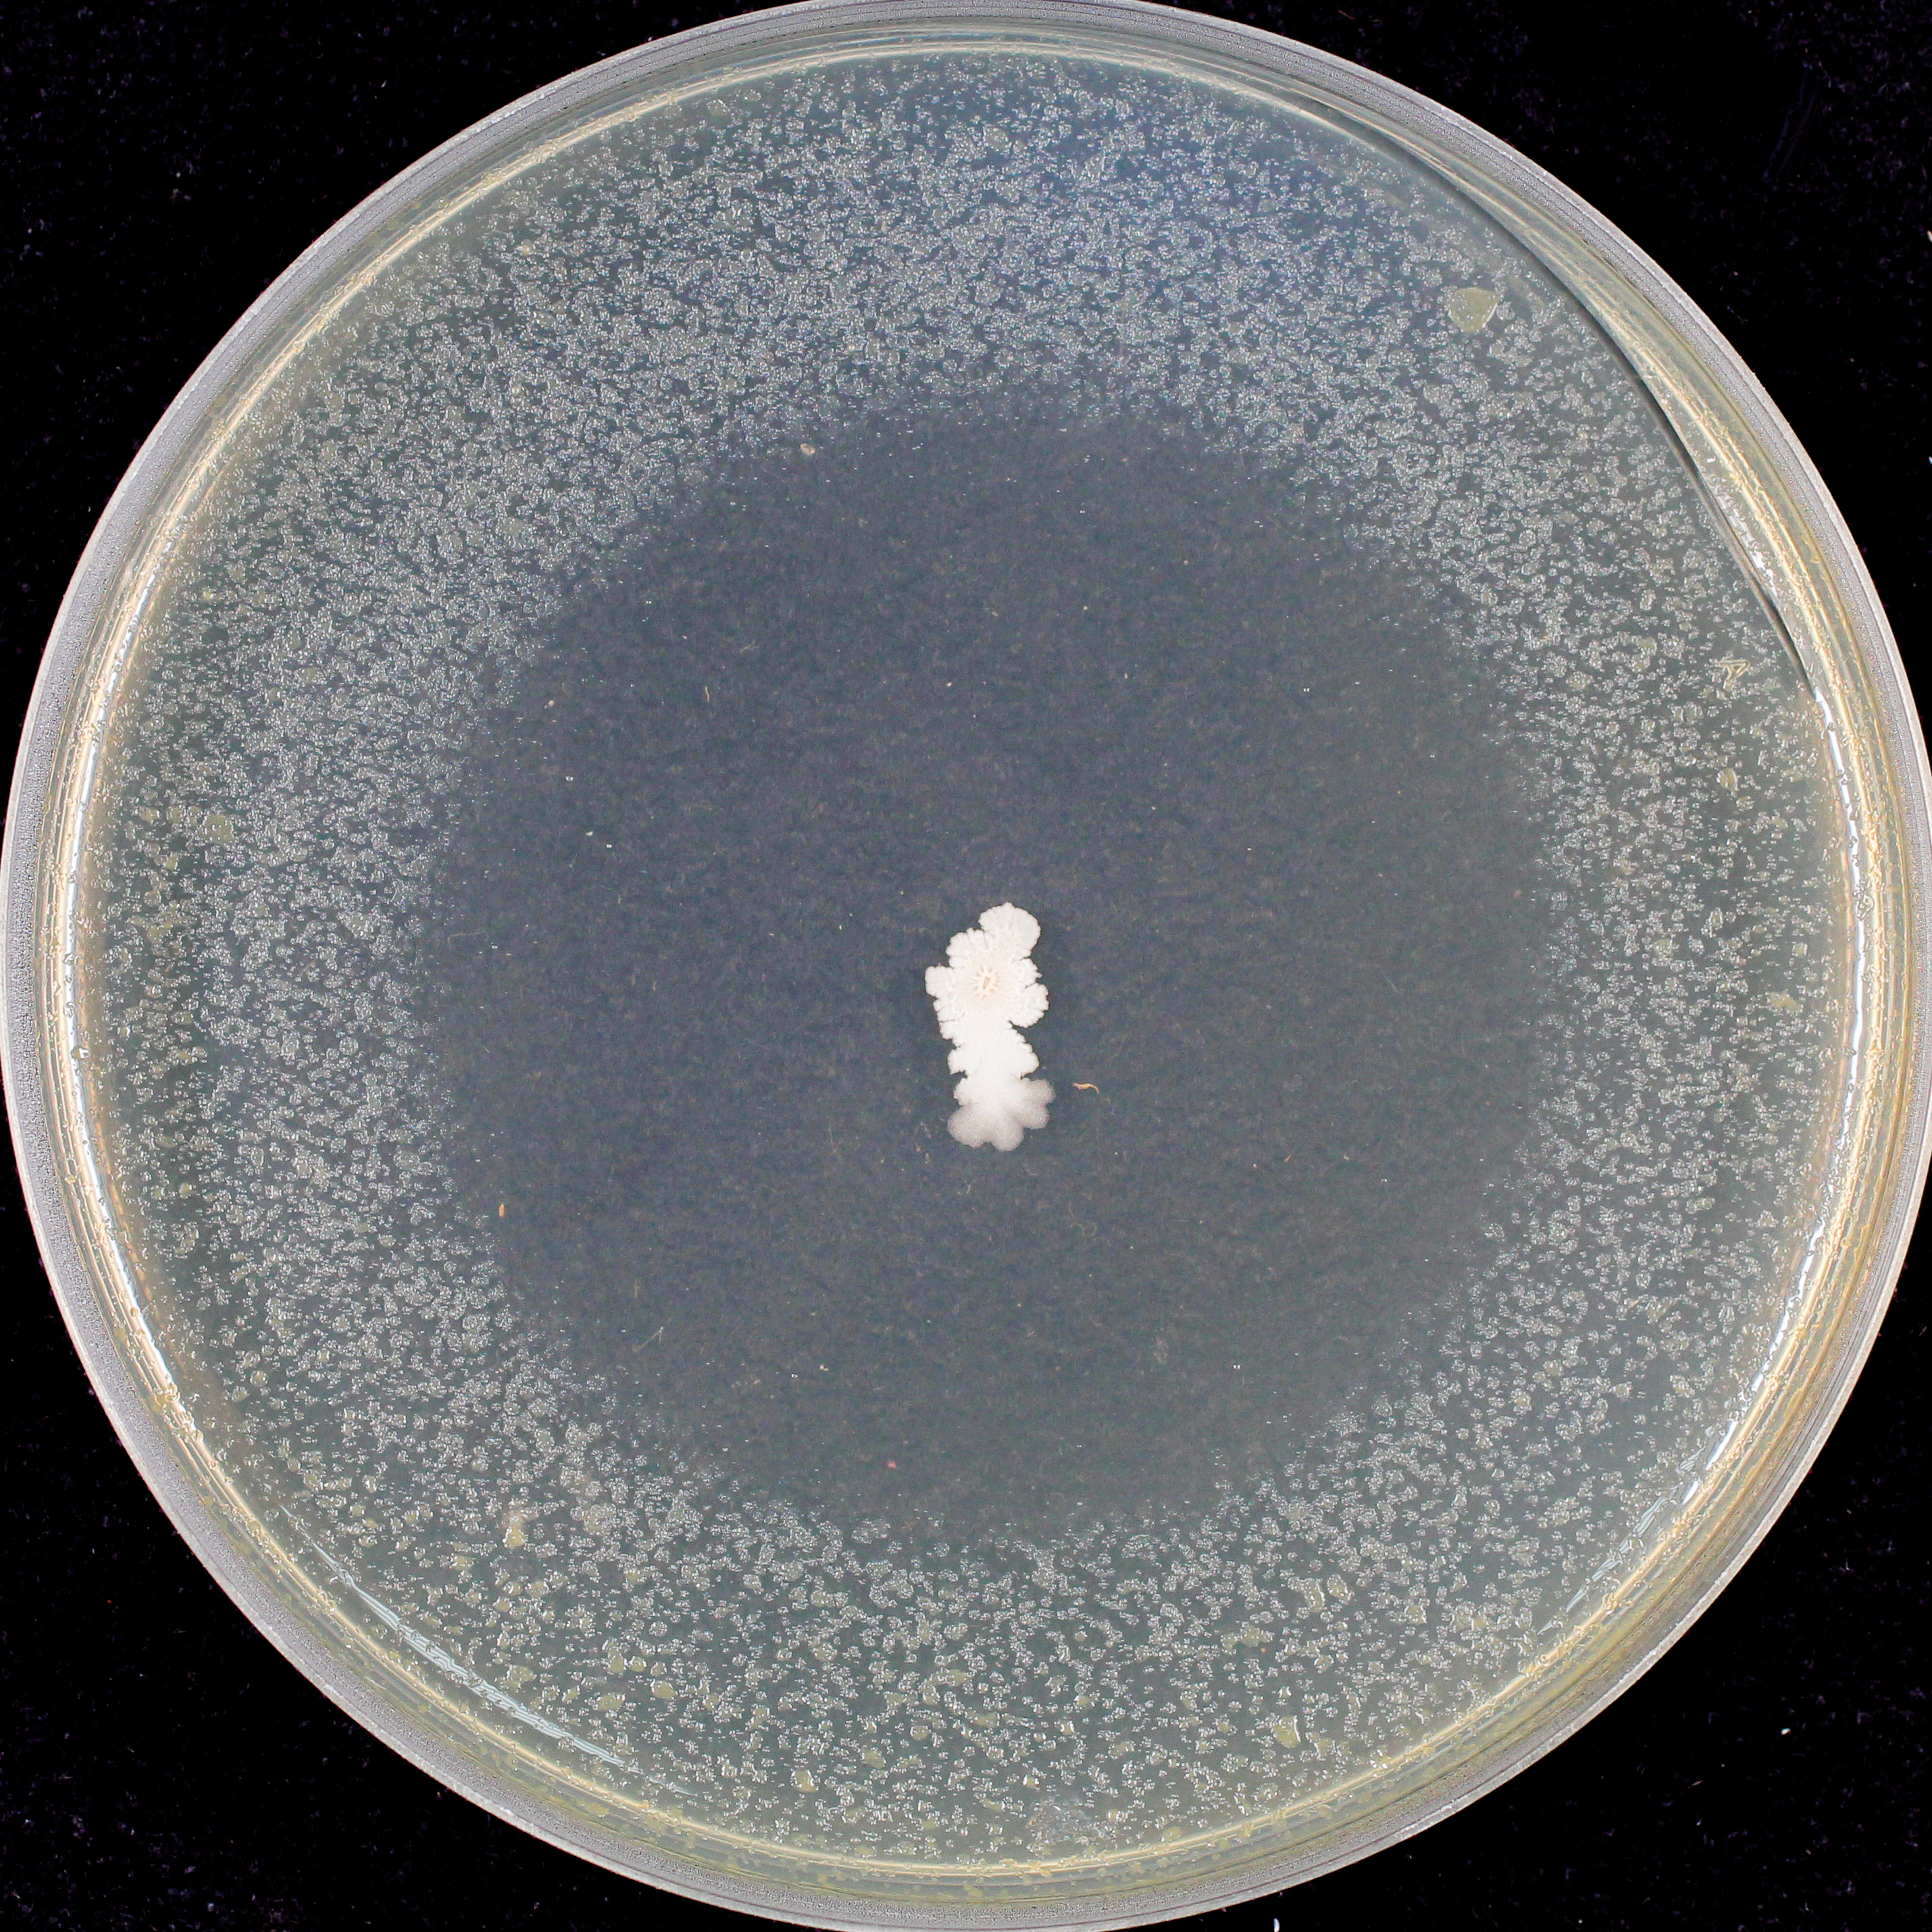

獲獎年度及獎項: 113國家發明創作獎 發明獎 銀牌
獲獎年度及獎項: 113國家發明創作獎 發明獎 銀牌
專利證號: I638889
參展單位: 農業部高雄區農業改良場
展品名稱: 枯草桿菌KHY8菌株及其增量培養方法與用途
Bacillus subtilis KHY8具多種抗生物質及箝鐵物質,有效抑制病原微生物生長;且具多種水解酵素及植物生長激素IAA,促進作物生長。田間試驗證實能有效防治稻熱病、芒果黑斑病及炭疽病等多種重要病害,並可與肥料及部分化學農藥共同使用。可用於製作生物農藥、生物肥料、堆肥、土壤改良劑及抑病介質,具多功性。在微生物農藥應用部分,本專利以500萬元技轉予業者製作微生物農藥商品,並通過政府登記審查,可用於水稻、芒果及咖啡等11種作物之病害防治。
- 發布日期:114-09-15
- 更新日期: 114-09-15
- 發布單位:專利行政企劃組
- 點閱次數:332